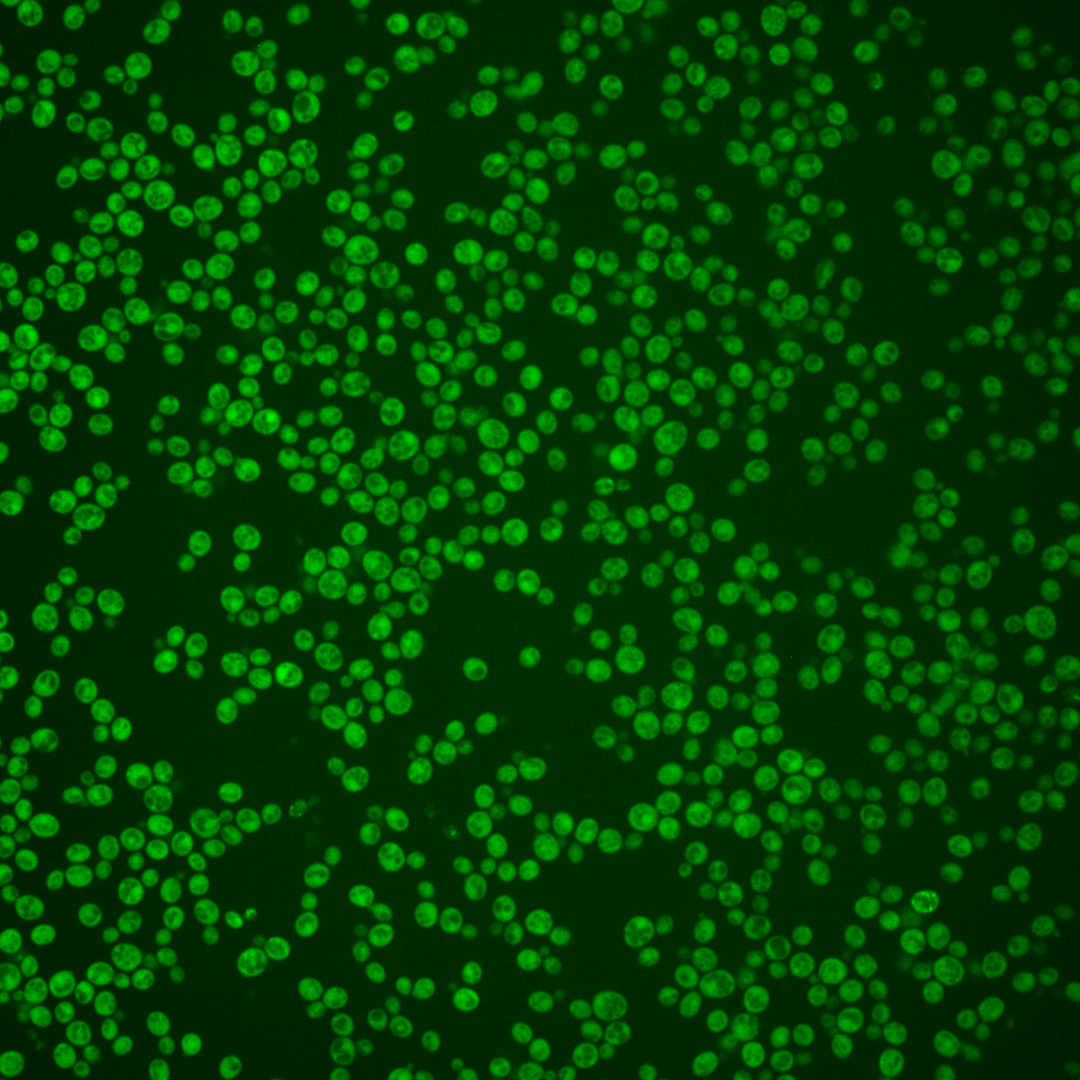
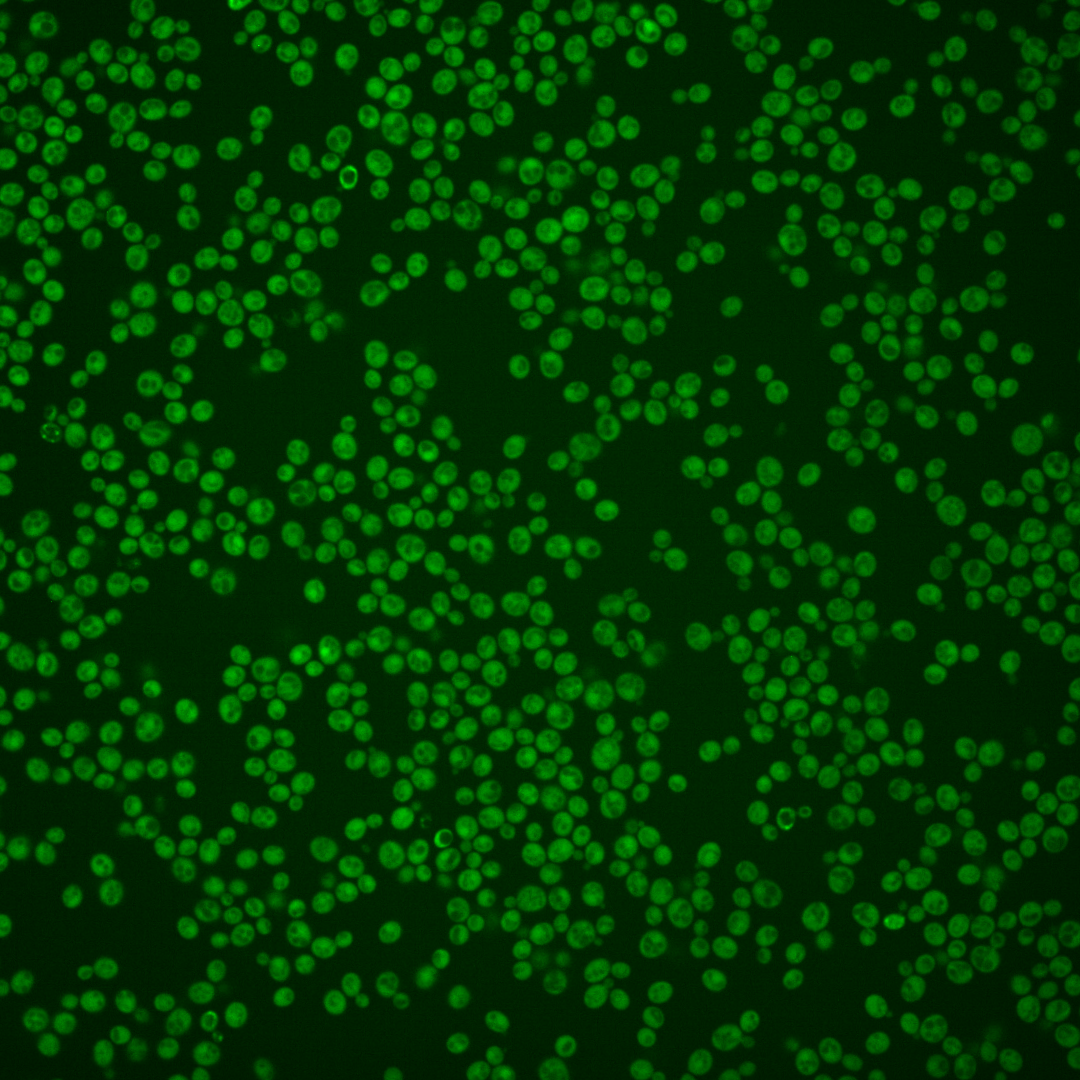
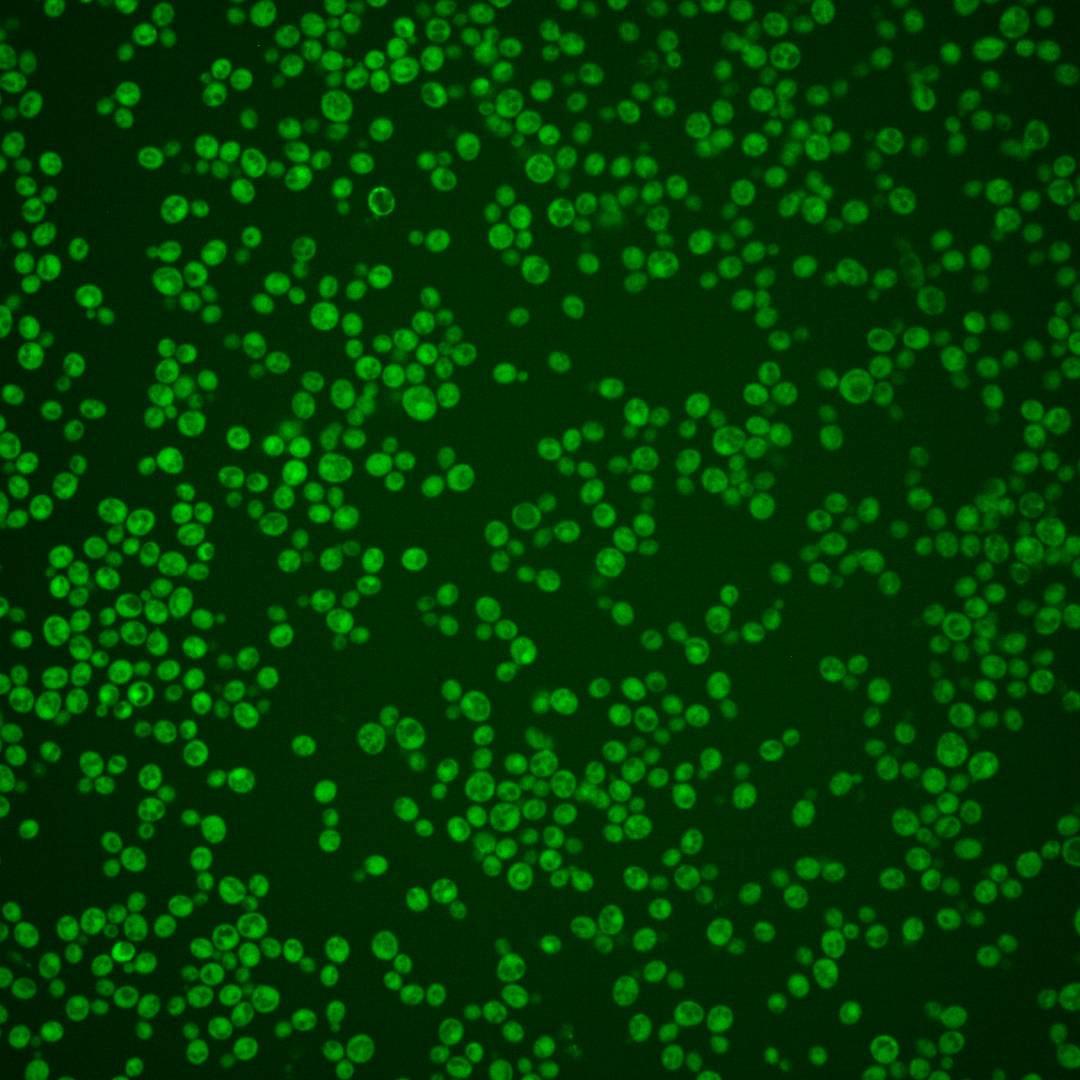

| Standard name | |
|---|---|
| Human Ortholog | |
| Description | Cys2His2 zinc-finger transcriptional repressor; involved in alkaline responsive gene repression as part of adaptation to alkaline conditions; involved in cell wall assembly; required for alkaline pH-stimulated haploid invasive growth and sporulation; activated by alkaline-dependent proteolytic processing which results in removal of the C-terminal tail; similar to A. nidulans PacC |
Micrographs




















































































Sub-cellular Localization
Yeast GFP Assignment
Protein Abundance
Localization Change
External localization resources
| ensLOC | DeepLoc | |||||||||||||||||||||||
|---|---|---|---|---|---|---|---|---|---|---|---|---|---|---|---|---|---|---|---|---|---|---|---|---|
| Localization | WT1 | WT2 | WT3 | RAP60 | RAP140 | RAP220 | RAP300 | RAP380 | RAP460 | RAP540 | RAP620 | RAP700 | HU80 | HU120 | HU160 | rpd3Δ_1 | rpd3Δ_2 | rpd3Δ_3 | WT1 | WT2 | WT3 | AF100 | AF140 | AF180 |
| Cortical Patches | 0 | 0 | 0 | 0 | 0 | 0 | 4 | – | 1 | 1 | 1 | 0 | 0 | 0 | 0 | 2 | 1 | 0 | 0 | 0 | 0 | 0 | 0 | 0 |
| Bud | 0 | 0 | 1 | 0 | 1 | 0 | 7 | – | 3 | 6 | 7 | 10 | 1 | 0 | 0 | 0 | 1 | 0 | 0 | 0 | 0 | 0 | 2 | 2 |
| Bud Neck | 0 | 0 | 0 | 0 | 0 | 1 | 0 | – | 1 | 4 | 1 | 1 | 0 | 0 | 0 | 0 | 0 | 0 | 0 | 0 | 0 | 0 | 0 | 0 |
| Bud Site | 0 | 0 | 0 | 0 | 0 | 0 | 1 | – | 0 | 0 | 0 | 0 | 0 | 0 | 0 | 0 | 0 | 0 | – | – | – | – | – | – |
| Cell Periphery | 0 | 11 | 7 | 9 | 8 | 9 | 10 | – | 0 | 1 | 3 | 2 | 0 | 6 | 6 | 36 | 20 | 24 | 0 | 0 | 0 | 0 | 0 | 0 |
| Cytoplasm | 189 | 187 | 133 | 213 | 311 | 348 | 488 | – | 184 | 321 | 300 | 393 | 60 | 254 | 301 | 248 | 267 | 152 | 185 | 181 | 135 | 65 | 188 | 188 |
| Endoplasmic Reticulum | 0 | 1 | 0 | 0 | 1 | 0 | 1 | – | 1 | 5 | 0 | 14 | 1 | 3 | 0 | 13 | 11 | 14 | 0 | 0 | 1 | 0 | 0 | 0 |
| Endosome | 0 | 0 | 1 | 0 | 0 | 1 | 3 | – | 3 | 1 | 2 | 0 | 0 | 0 | 0 | 4 | 2 | 1 | 0 | 0 | 1 | 0 | 0 | 0 |
| Golgi | 0 | 0 | 0 | 0 | 2 | 0 | 0 | – | 0 | 0 | 0 | 0 | 0 | 0 | 0 | 3 | 4 | 2 | 0 | 0 | 0 | 0 | 0 | 0 |
| Mitochondria | 1 | 0 | 0 | 0 | 0 | 10 | 35 | – | 28 | 23 | 110 | 76 | 0 | 1 | 0 | 4 | 2 | 1 | 0 | 1 | 2 | 0 | 1 | 1 |
| Nucleus | 0 | 1 | 2 | 2 | 2 | 1 | 1 | – | 3 | 3 | 2 | 4 | 1 | 1 | 0 | 4 | 1 | 0 | 0 | 0 | 0 | 0 | 0 | 0 |
| Nuclear Periphery | 0 | 0 | 0 | 0 | 0 | 0 | 0 | – | 0 | 1 | 0 | 0 | 0 | 0 | 0 | 0 | 0 | 0 | 0 | 0 | 0 | 0 | 0 | 0 |
| Nucleolus | 0 | 0 | 0 | 0 | 0 | 0 | 0 | – | 0 | 0 | 0 | 0 | 0 | 0 | 0 | 0 | 1 | 0 | 0 | 0 | 0 | 0 | 0 | 0 |
| Peroxisomes | 0 | 0 | 0 | 0 | 0 | 0 | 0 | – | 0 | 0 | 0 | 0 | 0 | 0 | 0 | 0 | 0 | 0 | 0 | 0 | 0 | 0 | 0 | 0 |
| SpindlePole | 0 | 0 | 0 | 0 | 0 | 0 | 0 | – | 3 | 0 | 0 | 3 | 0 | 0 | 0 | 0 | 0 | 0 | 0 | 0 | 0 | 0 | 2 | 2 |
| Vac/Vac Membrane | 0 | 0 | 0 | 0 | 0 | 1 | 4 | – | 1 | 3 | 3 | 3 | 0 | 1 | 0 | 9 | 7 | 4 | 1 | 1 | 3 | 0 | 0 | 0 |
| Unique Cell Count | 189 | 188 | 135 | 213 | 314 | 353 | 516 | 208 | 350 | 369 | 463 | 62 | 257 | 301 | 273 | 281 | 158 | 189 | 186 | 148 | 66 | 202 | 202 | |
| Labelled Cell Count | 190 | 200 | 144 | 224 | 325 | 371 | 554 | 228 | 369 | 429 | 506 | 63 | 266 | 307 | 323 | 317 | 198 | 189 | 186 | 148 | 66 | 202 | 202 | |
Yeast GFP Assignment
Protein Abundance
| Screen | WT1 | WT2 | WT3 | RAP60 | RAP140 | RAP220 | RAP300 | RAP380 | RAP460 | RAP540 | RAP620 | RAP700 | HU80 | HU120 | HU160 | rpd3Δ_1 | rpd3Δ_2 | rpd3Δ_3 | AF100 | AF140 | AF180 |
|---|---|---|---|---|---|---|---|---|---|---|---|---|---|---|---|---|---|---|---|---|---|
| Mean Cell GFP Intensity (1e-4) | 5.7 | 6.9 | 6.4 | 7.3 | 7.4 | 5.8 | 5.5 | – | 4.7 | 4.7 | 4.2 | 4.5 | 6.8 | 7.8 | 6.9 | 9.7 | 10.1 | 10.3 | 5.7 | 6.6 | 6.6 |
| Std Deviation (1e-4) | 0.8 | 1.1 | 0.9 | 1.1 | 1.1 | 1.1 | 1.0 | – | 1.1 | 0.8 | 0.8 | 0.7 | 0.8 | 1.1 | 1.0 | 2.1 | 2.2 | 2.4 | 0.6 | 1.2 | 1.2 |
| Intensity Change (Log2) | – | – | – | 0.19 | 0.21 | -0.15 | -0.22 | – | -0.44 | -0.45 | -0.62 | -0.53 | 0.08 | 0.28 | 0.1 | 0.59 | 0.65 | 0.67 | -0.17 | 0.03 | 0.03 |
Localization Change
| Localization | RAP60 | RAP140 | RAP220 | RAP300 | RAP380 | RAP460 | RAP540 | RAP620 | RAP700 | HU80 | HU120 | HU160 | rpd3Δ_1 | rpd3Δ_2 | rpd3Δ_3 |
|---|---|---|---|---|---|---|---|---|---|---|---|---|---|---|---|
| Cortical Patches | 0 | 0 | 0 | 0 | – | 0 | 0 | 0 | 0 | 0 | 0 | 0 | 0 | 0 | 0 |
| Bud | 0 | 0 | 0 | 0 | – | 0 | 0 | 0 | 0 | 0 | 0 | 0 | 0 | 0 | 0 |
| Bud Neck | 0 | 0 | 0 | 0 | – | 0 | 0 | 0 | 0 | 0 | 0 | 0 | 0 | 0 | 0 |
| Bud Site | 0 | 0 | 0 | 0 | – | 0 | 0 | 0 | 0 | 0 | 0 | 0 | 0 | 0 | 0 |
| Cell Periphery | -0.4 | 0 | 0 | 0 | – | 0 | 0 | 0 | 0 | 0 | 0 | 0 | 2.5 | 0.7 | 2.8 |
| Cytoplasm | 1.8 | 0.5 | 0.1 | -1.9 | – | -3.4 | -2.7 | -4.9 | -4.3 | -0.8 | 0.3 | 2.1 | -2.9 | -1.7 | -1.2 |
| Endoplasmic Reticulum | 0 | 0 | 0 | 0 | – | 0 | 0 | 0 | 0 | 0 | 0 | 0 | 0 | 0 | 3.5 |
| Endosome | 0 | 0 | 0 | 0 | – | 0 | 0 | 0 | 0 | 0 | 0 | 0 | 0 | 0 | 0 |
| Golgi | 0 | 0 | 0 | 0 | – | 0 | 0 | 0 | 0 | 0 | 0 | 0 | 0 | 0 | 0 |
| Mitochondria | 0 | 0 | 0 | 3.1 | – | 0 | 0 | 0 | 0 | 0 | 0 | 0 | 0 | 0 | 0 |
| Nucleus | 0 | 0 | 0 | 0 | – | 0 | 0 | 0 | 0 | 0 | 0 | 0 | 0 | 0 | 0 |
| Nuclear Periphery | 0 | 0 | 0 | 0 | – | 0 | 0 | 0 | 0 | 0 | 0 | 0 | 0 | 0 | 0 |
| Nucleolus | 0 | 0 | 0 | 0 | – | 0 | 0 | 0 | 0 | 0 | 0 | 0 | 0 | 0 | 0 |
| Peroxisomes | 0 | 0 | 0 | 0 | – | 0 | 0 | 0 | 0 | 0 | 0 | 0 | 0 | 0 | 0 |
| SpindlePole | 0 | 0 | 0 | 0 | – | 0 | 0 | 0 | 0 | 0 | 0 | 0 | 0 | 0 | 0 |
| Vacuole | 0 | 0 | 0 | 0 | – | 0 | 0 | 0 | 0 | 0 | 0 | 0 | 0 | 0 | 0 |
External localization resources
Images






























Protein Concentration and Protein Localization Data
| R1 | R2 | R3 | ||||||||||||||||
|---|---|---|---|---|---|---|---|---|---|---|---|---|---|---|---|---|---|---|
| G1 Pre-START | G1 Post-START | S/G2 | Metaphase | Anaphase | Telophase | G1 Pre-START | G1 Post-START | S/G2 | Metaphase | Anaphase | Telophase | G1 Pre-START | G1 Post-START | S/G2 | Metaphase | Anaphase | Telophase | |
| Concentration | 3.0008 | 5.0894 | 4.3204 | 3.8214 | 4.0729 | 3.9463 | 5.0595 | 6.7172 | 6.0538 | 5.764 | 5.206 | 5.8098 | 3.2159 | 5.3269 | 4.4178 | 4.3733 | 4.0145 | 4.297 |
| Actin | 0.0365 | 0.0004 | 0.0139 | 0.0282 | 0.0434 | 0.0024 | 0.0266 | 0.0002 | 0.0085 | 0.0162 | 0.0035 | 0.0018 | 0.0642 | 0.0003 | 0.0237 | 0.0024 | 0.0005 | 0.0026 |
| Bud | 0.0007 | 0.0002 | 0.0004 | 0.0061 | 0.0004 | 0.0002 | 0.001 | 0.0002 | 0.001 | 0.0032 | 0.0004 | 0.0005 | 0.0035 | 0.0022 | 0.004 | 0.0002 | 0.0001 | 0.0009 |
| Bud Neck | 0.0024 | 0.0001 | 0.0007 | 0.0084 | 0.0017 | 0.0007 | 0.0021 | 0.0001 | 0.0009 | 0.0021 | 0.0015 | 0.001 | 0.0041 | 0.0001 | 0.0004 | 0.0003 | 0.0004 | 0.0012 |
| Bud Periphery | 0.0006 | 0.0001 | 0.0004 | 0.0087 | 0.0003 | 0.0002 | 0.0012 | 0.0001 | 0.0015 | 0.0032 | 0.0003 | 0.0005 | 0.0046 | 0.0003 | 0.0015 | 0 | 0.0002 | 0.0009 |
| Bud Site | 0.0076 | 0.0014 | 0.0037 | 0.0096 | 0.0041 | 0.0003 | 0.0042 | 0.0004 | 0.0037 | 0.011 | 0.0005 | 0.0005 | 0.0114 | 0.0008 | 0.004 | 0.0002 | 0.0003 | 0.0078 |
| Cell Periphery | 0.0006 | 0.0004 | 0.0003 | 0.0009 | 0.0007 | 0.0001 | 0.0004 | 0.0001 | 0.0002 | 0.0002 | 0.0001 | 0.0001 | 0.0006 | 0.0001 | 0.0001 | 0 | 0.0001 | 0.0001 |
| Cytoplasm | 0.7802 | 0.9764 | 0.9157 | 0.8081 | 0.9221 | 0.944 | 0.7906 | 0.9626 | 0.9045 | 0.8769 | 0.8061 | 0.943 | 0.7208 | 0.9816 | 0.9123 | 0.9256 | 0.8493 | 0.9441 |
| Cytoplasmic Foci | 0.0342 | 0.0029 | 0.0145 | 0.0134 | 0.0061 | 0.005 | 0.0222 | 0.0073 | 0.0125 | 0.0216 | 0.0481 | 0.0088 | 0.034 | 0.0026 | 0.0078 | 0.0261 | 0.0044 | 0.0066 |
| Eisosomes | 0.0004 | 0 | 0.0001 | 0.0007 | 0.0002 | 0.0001 | 0.0002 | 0 | 0.0001 | 0.0001 | 0.0001 | 0 | 0.0003 | 0 | 0.0001 | 0 | 0 | 0 |
| Endoplasmic Reticulum | 0.0066 | 0.0031 | 0.0032 | 0.0037 | 0.003 | 0.002 | 0.0113 | 0.0014 | 0.0043 | 0.0037 | 0.0044 | 0.0037 | 0.0183 | 0.0018 | 0.0025 | 0.0018 | 0.0043 | 0.0058 |
| Endosome | 0.0305 | 0.0019 | 0.0177 | 0.0235 | 0.0064 | 0.0093 | 0.0411 | 0.006 | 0.0193 | 0.021 | 0.0483 | 0.0093 | 0.0316 | 0.0011 | 0.0086 | 0.0068 | 0.0323 | 0.0102 |
| Golgi | 0.0117 | 0.0002 | 0.0073 | 0.0232 | 0.0029 | 0.0056 | 0.0134 | 0.0006 | 0.0088 | 0.0059 | 0.0147 | 0.0023 | 0.0117 | 0.0001 | 0.0029 | 0.0009 | 0.0017 | 0.0022 |
| Lipid Particles | 0.009 | 0.0001 | 0.0048 | 0.0115 | 0.0007 | 0.0041 | 0.0106 | 0.0005 | 0.0043 | 0.0006 | 0.0143 | 0.0022 | 0.0084 | 0 | 0.0039 | 0.0059 | 0.0052 | 0.0018 |
| Mitochondria | 0.0034 | 0.0001 | 0.0056 | 0.0045 | 0.0002 | 0.0183 | 0.0091 | 0.0003 | 0.0051 | 0.0043 | 0.0282 | 0.0144 | 0.0174 | 0.0003 | 0.0094 | 0.0001 | 0.0039 | 0.0072 |
| None | 0.0385 | 0.0104 | 0.0053 | 0.0062 | 0.0039 | 0.0041 | 0.021 | 0.0172 | 0.0131 | 0.0179 | 0.0126 | 0.0016 | 0.0204 | 0.0065 | 0.0061 | 0.0037 | 0.0607 | 0.0018 |
| Nuclear Periphery | 0.0025 | 0.0004 | 0.0009 | 0.0021 | 0.0005 | 0.0005 | 0.0098 | 0.0003 | 0.0013 | 0.0013 | 0.0008 | 0.0025 | 0.0068 | 0.0003 | 0.0009 | 0.0008 | 0.0173 | 0.0005 |
| Nucleolus | 0.0007 | 0 | 0.0001 | 0.0011 | 0 | 0.0001 | 0.0009 | 0 | 0.0002 | 0.0002 | 0.0001 | 0.0004 | 0.0007 | 0.0001 | 0.0001 | 0.0001 | 0.0009 | 0.0003 |
| Nucleus | 0.0012 | 0.0006 | 0.0007 | 0.0018 | 0.0007 | 0.0005 | 0.012 | 0.0007 | 0.0014 | 0.0028 | 0.0011 | 0.0019 | 0.004 | 0.0009 | 0.0008 | 0.001 | 0.0048 | 0.0009 |
| Peroxisomes | 0.0092 | 0 | 0.0019 | 0.0059 | 0.0002 | 0.0014 | 0.0121 | 0.001 | 0.003 | 0.0029 | 0.0108 | 0.0017 | 0.0122 | 0 | 0.0085 | 0.008 | 0.0002 | 0.0033 |
| Punctate Nuclear | 0.0203 | 0.0001 | 0.0004 | 0.0047 | 0.0002 | 0.0002 | 0.0026 | 0.0001 | 0.0028 | 0.0012 | 0.0005 | 0.001 | 0.0186 | 0.0001 | 0.0007 | 0.013 | 0.0023 | 0.0005 |
| Vacuole | 0.0025 | 0.001 | 0.002 | 0.022 | 0.0019 | 0.0007 | 0.0062 | 0.001 | 0.0028 | 0.0033 | 0.0028 | 0.002 | 0.0047 | 0.0007 | 0.0013 | 0.0025 | 0.0059 | 0.0011 |
| Vacuole Periphery | 0.0007 | 0.0001 | 0.0005 | 0.0057 | 0.0005 | 0.0005 | 0.0016 | 0.0002 | 0.0007 | 0.0007 | 0.0009 | 0.0009 | 0.0016 | 0.0001 | 0.0003 | 0.0003 | 0.0053 | 0.0003 |
Sequencing Data
| R1 | R2 | |||||||||
|---|---|---|---|---|---|---|---|---|---|---|
| G1 Post-START | S/G2 | Metaphase | Anaphase | Telophase | G1 Post-START | S/G2 | Metaphase | Anaphase | Telophase | |
| Gene Expression | 18.8014 | 14.7064 | 21.4358 | 22.4866 | 20.5679 | 17.6165 | 23.2337 | 26.1652 | 28.9999 | 28.1755 |
| Translational Efficiency | 1.9368 | 2.599 | 1.4095 | 1.3949 | 1.8929 | 2.2592 | 1.512 | 1.6328 | 1.3933 | 1.3214 |
Hit Data
| Dataset | Hit |
|---|---|
| Protein Concentration | ✘ |
| Protein Localization | ✘ |
| Gene Expression | ✔ |
| Translational Efficiency | ✘ |
Endocytosis
| Temp | Actin Patch (Sac6-tdTomato) | Cortical Patch (Sla1-GFP) | Late Endosome (Snf7-GFP) | Vacuole (Vph1-GFP) |
|---|---|---|---|---|
| 37℃ | ||||
| RT |
Cell Cycle Omics
CYCLoPs (Rim101-GFP)
| Gene / Allele | Actin Patch (Sac6-tdTomato) | Cortical Patch (Sla1-GFP) | Late Endosome (Snf7-GFP) | Vacuole (Sac6-tdTomato) |
|---|
| Gene | Images |
|---|
| Gene | Images |
|---|
Images are not yet available
Images are not yet available